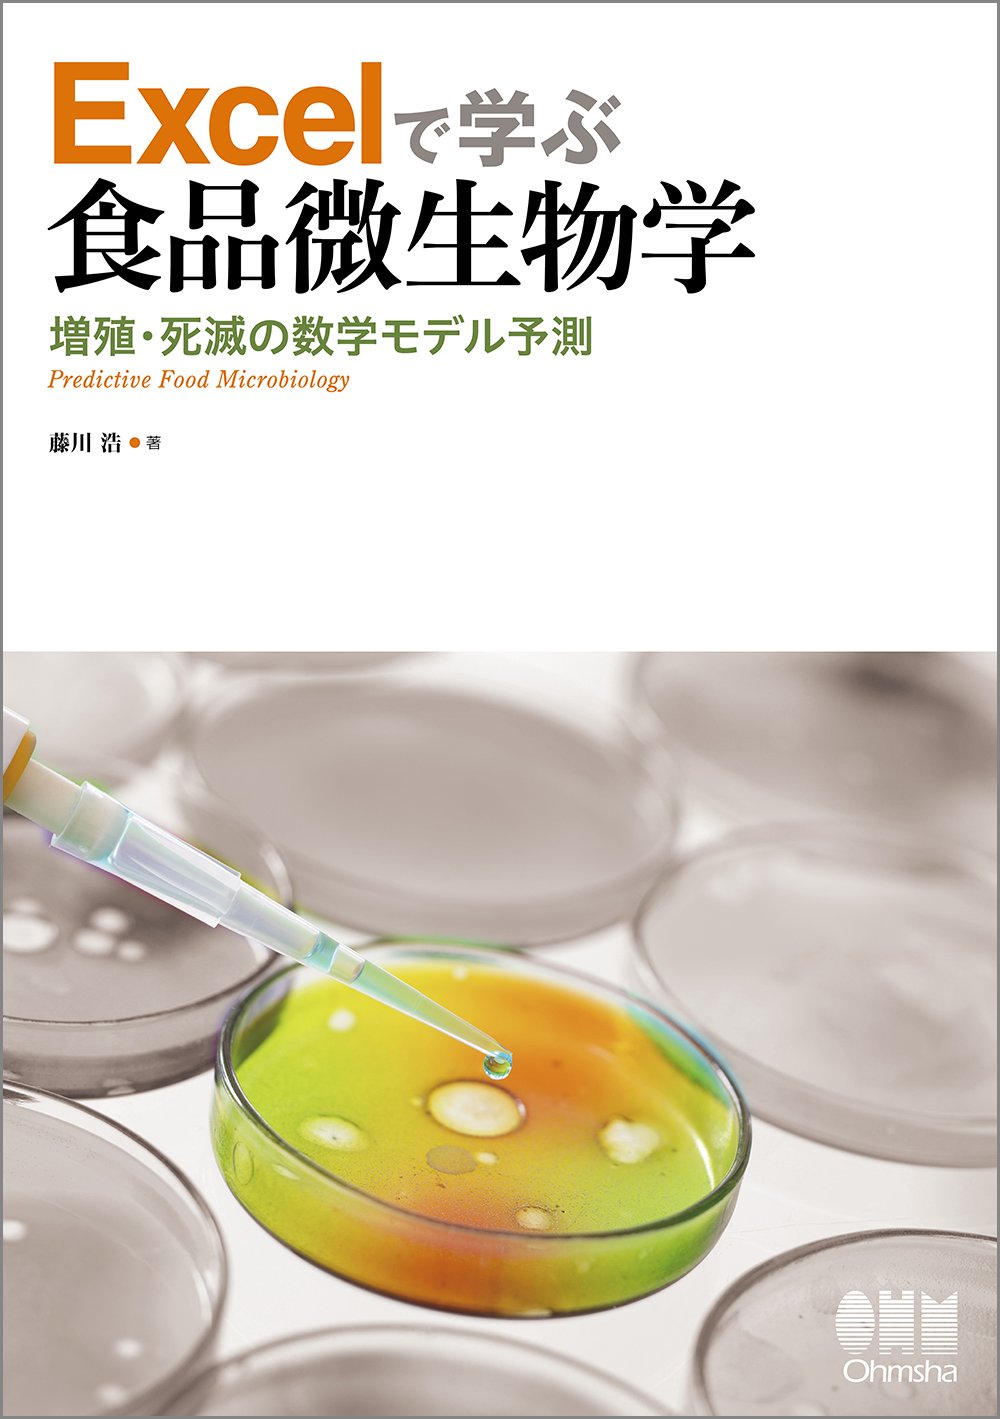
71mAiJL1BIL.jpg

マイストア
変更
お店で受け取る
(送料無料)
配送する
納期目安:
2026.01.29 17:17頃のお届け予定です。
決済方法が、クレジット、代金引換の場合に限ります。その他の決済方法の場合はこちらをご確認ください。
※土・日・祝日の注文の場合や在庫状況によって、商品のお届けにお時間をいただく場合がございます。
Brock微生物学 美品 廃盤品 81ZoTrKGaqL.jpgの詳細情報
81ZoTrKGaqL.jpg。食品微生物学 | 高見 伸治 |本 | 通販 | Amazon。新・微生物学 新装第2版』(NPO法人日本バイオ技術教育学会,別府。Brock微生物学 Brock微生物学 美品 廃盤品 Brock微生物学(Michaei.T。「Brock微生物学」Madigan Michael T / Martinko John M / Jack Parker / 室伏 きみ子 / 関 啓子定価: ¥ 18000#MadiganMichaelT #Madigan_Michael_T #MartinkoJohnM #Martinko_John_M #JackParker #Jack_Parker #室伏きみ子 #室伏_きみ子 #関啓子 #関_啓子 #本 #電気・機械/電気
ベストセラーランキングです
近くの売り場の商品
カスタマーレビュー
オススメ度 4.7点
現在、6267件のレビューが投稿されています。